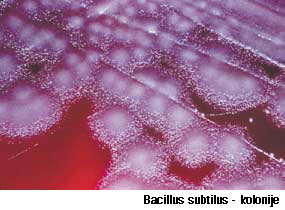

Sačuvajmo lijep i zdrav kruh što duže
Nitavost kruha izazivaju mikroorganizmi bakterije i plijesni, a pogoduju im vlažni i topli uvjeti, pa namirnice treba čuvati na hladnom i tamnom mjestu, a SANOPAN i AMIPAN T dodatno će spriječiti kvarenje.
Ljudi su oduvijek nastojali zaštititi hranu od kvarenja i produžiti joj vrijeme u kojem će sačuvati početna svojstva, kako u izgledu i okusu, tako i po zdravstvenoj ispravnosti.
Glavni krivci kvarenja hrane su mikroorganizmi koji su prisutni svugdje oko nas i u povoljnim uvjetima počinju rasti i razmnožavati se na bilo čemu što je za njih hranjivo. Kad se namnože u dovoljnoj količini, hrana postane zdravstveno neispravna, jer mikroorganizmi uneseni u probavni sustav čovjeka mogu izazvati različite probavne smetnje, a poneki i teže zdravstvene probleme.
Brašno i ostale sirovine za proizvodnju pekarskih proizvoda te sami pekarski proizvodi nisu nikakav izuzetak i jednako su podložni kvarenju i tada postaju opasni za zdravlje. Ponekad se to kvarenje u početku ne vidi, ali je ubrzo vrlo uočljivo na površini i u sredini pekarskog proizvoda kao manje ili veće točke u različitim bojama – to su kolonije plijesni i bakterija. Pojedine vrste plijesni i bakterija proizvode i otrove te su još opasnije ako se kruhom unesu u organizam.
I bakterijama i plijesnima pogoduje toplo i vlažno vrijeme te puno hranjivih sastojaka u kruhu i raznim pekarskim proizvodima, pa se vrlo brzo razmnožavaju. Nemoguće ih je izbjeći, jer su prisutni i u zraku, na radnim plohama i strojevima, dolaze u sirovinama, ali ih je primjenom određenih higijenskih mjera i dodatkom odgovarajućih konzervansa moguće smanjiti i spriječiti njihovo razmnožavanje te tako zaštititi pekarske proizvode od kvarenja i produžiti im rok trajnosti.
Bakterije su prastari jednostanični organizmi, pretpostavlja se da postoje već četiri milijarde godina. Mogu biti različitog oblika: okrugle, štapićaste, poput zareza ili spirale; mogu biti pokretne te u tekućem mediju vrlo brzo plivaju. Vrlo su malene – u prosjeku im je promjer manji od 1 mikrometra i pod mikroskopom se uglavnom vide samo ako se oboje. Kolonija bakterija naraste od jedne jedine bakterije koja je tada vidljiva prostim okom, a izgleda kao sluzava točka ili kružić na podlozi. Različitih su boja, ovisno o vrsti bakterija. Pojedine vrste bakterija postoje samo u vegetativnom obliku i ugibaju u nepovoljnim uvjetima, dok druge stvaraju spore koje mogu preæivjeti vrlo dugo i bez vlage, a otporne su i na povišenu temperaturu. Kada ponovno dođu u povoljne uvjete za rast, spora se otvori i bakterije se namnože.

Nitavost kruha
U pekarskim proizvodima najveće probleme stvaraju štapićaste bakterije iz roda Bacillus i to uglavnom Bacillus subtilis koja izaziva nitavost sredine kruha. To je bakterija koja u obliku spore čeka povoljne uvjete za razmnožavanje: toplu i vlažnu sredinu s dovoljno hrane. Ona je prisutna u zemlji te se u pekarske proizvode unese iz brašna koje se samljelo iz zrnja pšenice koje se inficiralo tijekom žetve.
Sredina kruha postaje ljepljiva na dodir i razdvajanjem komadića vidljive su fine sluzave ružičaste niti, poput vlažne paučine. Kruh ujedno ima i neugodan miris. Nitavost je teško uočiti, jer se ne primjećuje na kori kruha i zato treba biti oprezan. Brzina pojave nitavosti ovisi o početnom broju spora te bakterije u brašnu, tehnološkom procesu, temperaturi pečenja i uvjetima čuvanja pekarskih proizvoda. Što je manje početno zagađenje, uz povećanje kiselosti i niže vlage sredine kruha te čuvanja kruha na suhom i hladnom mjestu, to će se nitavost pojaviti kasnije, ili uopće ne, i pekarski će se proizvod moći konzumirati do predviđenog roka trajnosti.
Zaštita pekarskih proizvoda
Najjednostavnije mjere zaštite kruha od nitavosti su uobičajeno čišćenje postrojenja i opreme, upotreba brašna sa što manjim brojem bakterija, dobro ispečena sredina kruha te dodavanje konzervansa koji će povećati kiselost sredine i tako spriječiti razmnožavanje bakterija. To je posebno važno ljeti kad je i temperatura i vlaga u zraku vrlo visoka, kruh se sporo hladi, a to su uvjeti koji savršeno odgovaraju bakterijama. U proizvode koji se izrađuju iz integralnih ili tamnijih tipova brašna s većim udjelom ljuske, a posebno uz dodatak posija, kao i u proizvode kojima je svojstveno da imaju vlažnu i sočnu sredinu, potrebno je dodavati konzervanse u bilo koje doba godine kako bi sačuvali svoja poželjna svojstva i bili zdravstveno ispravni.
KVASAC d.o.o. je davno spoznao probleme vezane uz nitavost i ponudio SANOPAN kao rješenje za sprečavanje nitavosti u svim pekarskim proizvodima. Aktivni sastojak SANOPANA je kalcijev acetat, tj. kalcijeva sol octene kiseline, koji djeluje tako da poveća kiselost sredine kruha i time blokira rast bakterija. Kalcijev acetat je potpuno prirodni sastojak, jer je, zapravo, samo jedan od oblika običnog octa koji normalno upotrebljavamo u hrani, a razlika je u tome što je točno određene koncentracije i uvijek je jednako aktivan i djelotvoran u zaštiti kruha od nitavosti. Dozira se 0,4-0,6% na brašno, dodaje se izravno u zamjes s ostalim sirovinama, ne ometa rad kvasca i ne utječe na okus i miris pekarskih proizvoda.
Plijesni na pekarskim proizvodima
Kvarenje pekarskih proizvoda koje je vidljivo na kori kao obojene pahuljaste tvorevine uzrokuju različite plijesni. Mogu biti bijele, žute, zelene, plave ili crne boje, praše se na dodir, imaju neugodan miris i mogu izazvati kašalj. Rastu na površini, ali puštaju "korjenčiće" u dubinu pekarskih proizvoda.

Pod mikroskopom izgledaju kao drvce: na površini imaju stabalce s granama na kojima su glavice pune novih spora za razmnožavanje, a u podlozi imaju nitaste tvorevine – korjenčiće. Na pekarskim se proizvodima pojavljuje više vrsta plijesni: Penicillium, Aspegillus, Rhizopus, Mucor, Cladosporium, Trichosporum itd. Neke od njih stvaraju otrovne spojeve – mikotoksine – koji mogu biti i kancerogeni. Sve rastu vrlo brzo i odgovara im uobičajena vlažnost pekarskih proizvoda, a pogoduje im i šećer u kolačima. Pekarske proizvode s vidljivim plijesnima treba odmah uništiti, jer su zdravstveno neispravni i štetni za zdravlje. Plijesni su vrlo osjetljive na temperaturu i plijesni unesene brašnom uglavnom se unište za vrijeme pečenja. Kruh se neće kvariti rastom plijesni iz sredine, nego naknadnim zagađenjem kore pečenog proizvoda plijesnima iz okoline: iz zraka, s površine stolova, ruku djelatnika i sl. Za sprečavanje se upotrebljavaju konzervansi, uz ostale mjere površinske zaštite kao prekrivanje tijekom hlađenja i pakiranje u nepropusnu ambalažu. Djelotvornu zaštitu daju propionska i sorbinska kiselina te njihove soli.
Zaštita pekarskih proizvoda
AMIPAN T je tekuće sredstvo na bazi propionske kiseline u kombinaciji s mliječnom kiselinom za sprečavanje razvoja plijesni u svježim pekarskim proizvodima, kolačima i keksima koji se prodaju upakirani. Također se može dodavati u listove za savijače i krumpirove njoke.
Dozira se u količini od 2 do 5% računajući na masu proizvoda ili brašno ovisno o vrsti proizvoda, vodeći računa da ne smije biti više od 2g propionske kiseline po kg gotovog proizvoda spremnog za jelo.
Dodatkom AMIPANA T mogu se proizvoditi trajniji proizvodi koji se upakiraju, kao npr. toast kruh.
Toast kruh je posebna vrsta kruha produžene trajnosti. Pečen je u zatvorenom kalupu, narezan na kriške i upakiran. Posebna svojstva su mu da ima mekanu koru, ujednačeno fino poroznu sočnu sredinu, blago slatki aromatični okus, produženu svježinu i, kao najvažnije, da se može dobro ispržiti u tosteru u hrskavu kriπku ili sendvič.
AMIPAN T, osim što će spriječiti rast plijesni, olakšava postizanje pravilne strukture i mekoće sredine i sprečava isušivanje sredine, jer sadrži sredstvo za zadržavanje vlage. Dodatkom mlijeka, šećera, masnoće i ostalih sastojaka neophodnih za izradu kvalitetnog toast kruha, uz AMIPAN T možete biti sigurni u trajnost i kakvoću svojeg proizvoda.

